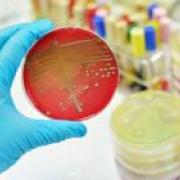
Bactéries
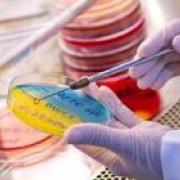
microbilogie

|
 |
 |
 |
 |
 |
|
m.derouag@univ-batna2.dz |
 |
 |
|
Département d´Electrotechnique |
 |
Maître conférence classe - B |
Enseignant Chercheur |
 |
 |
 |
 |
 |
 |
 |
Teacher of English |
|